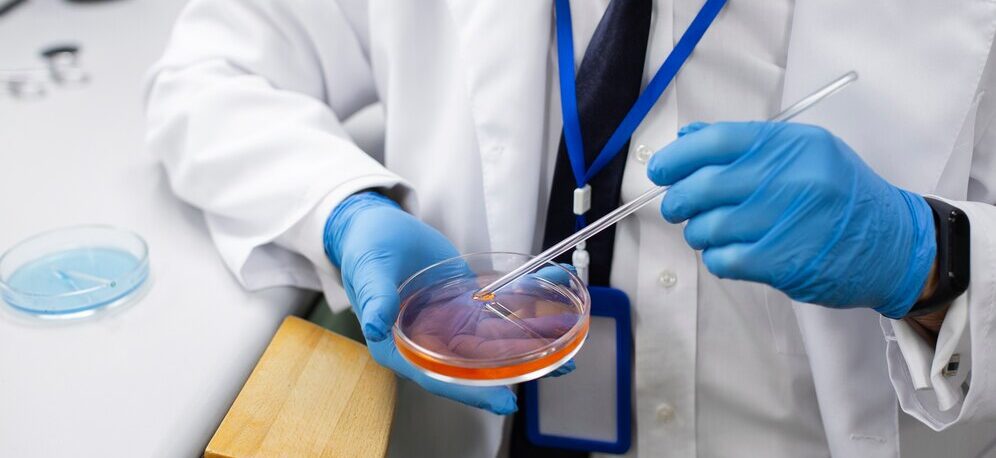

Para Quem a Fertilização In Vitro é Indicada?
A FIV pode ser feita da forma tradicional, onde o óvulo é exposto a sêmen em uma placa de laboratório e assim se aguarda o processo de fertilização ou através da ICSI, uma técnica onde se injeta o espermatozoide selecionado dentro do óvulo. As indicações variam, mas de maneira geral se aplicam nos casos abaixo.
Problemas no sêmen:
Quantidade insuficiente, baixa mobilidade ou alterações na forma dos espermatozoides.
Azoospermia obstrutiva:
Ausência de espermatozoides devido a obstruções no trajeto de saída, como vasectomia, malformações congênitas ou sequelas de infecções.
Azoospermia não-obstrutiva:
Ausência de produção de espermatozoides, podendo ser necessário o uso de sêmen de doador.
Problemas nas trompas:
Obstrução ou dilatação das trompas de Falópio (hidrossalpinge), causadas por infecções, cirurgias prévias (como laqueadura) ou endometriose.
Endometriose e adenomiose.
Baixa reserva ovariana:
Diminuição na quantidade ou qualidade dos óvulos, identificada por idade materna avançada ou exames hormonais.
Doenças genéticas hereditárias:
Casais com histórico de condições como fibrose cística ou distrofias musculares podem realizar testes genéticos pré-implantacionais (PGT) para evitar a transmissão da doença aos filhos.
Alterações cromossômicas:
Indivíduos com alterações no cariótipo podem recorrer à PGT para selecionar embriões saudáveis.
Infertilidade sem causa aparente (ISCA).
Insucesso em outros tratamentos de reprodução assistida, como inseminação artificial e coito programado.